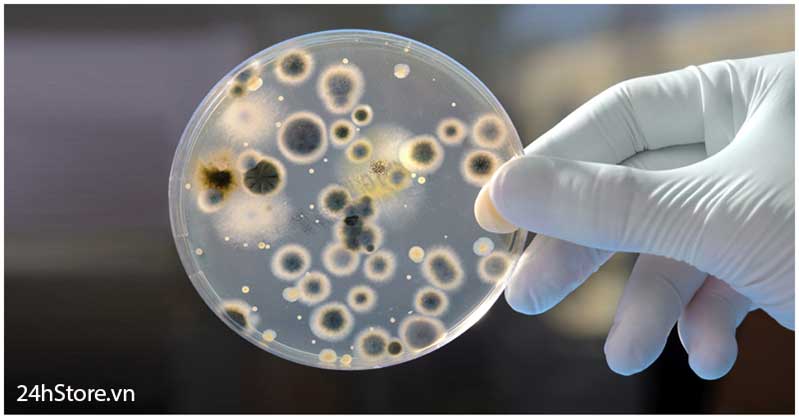
Tác hại của điện thoại

Phủ Nano Chống Nước
SUPER NANO – Công nghệ sẽ thay đổi hoàn toàn cuộc sống của bạn !!!
Sử dụng dung dịch Nano cấp độ 3 – tầng cao nhất của công nghệ nano và đưa vào hệ thống máy chân không phun sương công nghiệp giúp tạo thành 1 lớp khí bảo vệ vô hình cực kỳ hoàn hảo.
Lớp bảo vệ này không những mang lại cho điện thoại khả năng chống nước, chống ăn mòn siêu hạng mà còn có thể chống lại sự tấn công của các chất lỏng khác như Nước Ngọt,Nước ép trái cây, Bia…
Đặc biệt khả năng chống tĩnh điện, bức xạ nhiệt đồng thời tiêu diệt 99% vi khuẩn, ký sinh trùng trên điện thoại của Super Nano được FDA – Cục quản lý thực phẩm và dược phẩm Hoa Kỳ kiểm định và chứng nhận là giải pháp bảo vệ toàn diện và tiên tiến nhất cho điện thoại và sức khỏe con người.

CÔNG NGHỆ NÀY CÓ THỰC SỰ AN TOÀN VÀ CẦN THIẾT? TẠI SAO NÊN SỬ DỤNG?
1. KHÔNG CÒN SỢ VÔ SINH, UNG THƯ NÃO VỚI CÔNG NGHỆ KHÁNG TĨNH ĐIỆN, BỨC XẠ NHIỆT
Tổ chức Y tế Thế giới liệt kê điện thoại di động vào danh sách thiết bị gây hại nghiêm trọng đến sức khỏe con người do 2 nguyên nhân chính:
- Gây ung thư não, u tế bào thần kinh do bức xạ phát ra từ sóng điện thoại khi nghe, gọi điện và sử dụng 3G, Wifi.
- Sóng tĩnh điện diệt 90% tinh trùng Gây vô sinh, yếu sinh lý và liệt dương ở đàn ông do thói quen bỏ điện thoại trong túi quần.
SUPER NANO tạo ra lớp khí từ trường di chuyển với vận tốc nhanh gấp 50 lần tốc độ âm thanh, làm chuyển hóa 80% năng lượng của sóng bức xạ và tĩnh điện qua đó giúp cơ thể con người không bị tiếp xúc trực tiếp với chất phóng xạ gây hại cho não, tim mạch, và bộ phận sinh dục.

2. "VÔ ĐỊCH THIÊN HẠ" VỀ KHẢ NĂNG CHỐNG NƯỚC !!
Hiện nay các dòng điện thoại Sony, Samsung sử dụng giải pháp chống nước bằng cách bịt kín các lỗ tiếp xúc và sử dụng gioăng cao su, giải pháp này chỉ mang tính chất đối phó và không hiệu quả vì chất lỏng vẫn len lỏi qua các khe tiếp xúc và chỉ cần sơ ý không đóng các nắp đậy thì điện thoại của bạn sẽ tiêu tùng.

Super Nano sử dụng công nghệ chống nước ngoại hạng cấp độ IPX7 bằng phương pháp phủ khí bảo vệ vô hình lên toàn bộ thiết bị và linh kiện trong máy, do đó chất lỏng sẽ dễ dàng bốc hơi hoặc chảy ra ngoài giúp linh kiện, bo mạch điện tử không bị thấm nước và hoạt động ổn định dù ngâm nước hàng giờ đồng hồ.
Nước, chất lỏng bị vón cục và không thể thấm vào bề mặt thiết bị được phủ bằng Super Nano.
Đây là công nghệ chống nước cho điện thoại di động tốt nhất thế giới hiện nay và được rất nhiều tập đoàn hàng đầu thế giới như Dell, Microsoft (Nokia Lumia), IBM, Xiaomi… nghiên cứu để ứng dụng vào các thiết bị điện tử.

3. DIỆT 99% VI KHUẨN HAY KÝ SINH TRÙNG XÂM NHẬP CƠ THỂ
Từ lâu, điện thoại di động luôn được coi là "ổ vi trùng di động" và "bẩn gấp 10 lần nắp toilet" do không được vệ sinh và diệt khuẩn thường xuyên. Không những thế hàng ngày bạn thường xuyên tiếp xúc và để điện thoại sát mặt, miệng khiến vi khuẩn gây bệnh càng dễ dàng xâm nhập cơ thể.
Bạn phân vân có nên phủ Super Nano?
Có lẽ chẳng cần giới thiệu nhiều về Sức mạnh diệt khuẩn, ký sinh trùng đã quá nổi tiếng trên toàn thế giới của Super Nano khi được ứng dụng liên tục vào hàng loạt thiết bị tủ lạnh, máy lạnh kháng khuẩn danh tiếng như Daikin, Panasonic, Samsung... và được các bệnh viện quốc tế cao cấp trang bị vào các phòng mổ kháng khuẩn hiện đại.
Hãy lựa chọn những gì tốt nhất cho sức khỏe của bạn!
4. CẢM ỨNG CỰC MƯỢT, CHỐNG TRẦY XƯỚC – KHÔNG CẦN DÙNG MIẾNG DÁN MÀN HÌNH !!
Tính năng của Super Nano nổi trội hơn hẳn so với miếng dán cường lực, hoặc những ốp lưng đang tiêu thụ trên thị trường. Không chỉ chống nước, còn tăng cường tính chịu lực chống trầy của màn hình, độ cứng của bề mặt kính điện thoại có thể đạt 9H (gần bằng kim cương 9,3H)
Do đó bất kể chìa khoá hay thứ gì để chung với điện thoại tiếp xúc cũng không ảnh hưởng đến màn hình, giúp tăng độ sáng cho màn hình và độ hiển thị màu sắc tuyệt đẹp, tương phản càng tự nhiên, không có bong bóng, không mỏi mắt.

5. PHỦ SIÊU TỐC - KHÔNG CẦN THÁO MÁY - GIÁ THÀNH CỰC RẺ - HIỆU QUẢ TRONG SUỐT 365 NGÀY
Điện thoại của bạn sẽ được đưa vào hệ thống máy phun chân không tự động hóa để phủ Super Nano lên toàn bộ linh kiện trong và ngoài máy trong suốt 40 phút.
Quá trình thực hiện hoàn toàn không cần bung máy, tháo máy do đó hoàn toàn không ảnh hưởng đến chế độ bảo hành chính hãng của điện thoại. Lớp bảo vệ có tác dụng trong vòng 1 năm và có khả năng ngâm, nhúng chìm điện thoại hoàn toàn trong nước từ 3-4 lần.
Chi phí thực hiện có thể dao động từ 100 ngàn đồng đến 300 ngàn đồng tùy thuộc vào kích thước của điện thoại.
Với hàng loạt tính năng siêu việt, Super Nano chắc chắn là giải pháp bảo vệ điện thoại và sức khỏe con người tốt nhất trên thế giới hiện nay 24hStore và Bệnh Viện Điện Thoại 24h đang là đơn vị phân phối độc quyền công nghệ này ở Việt Nam.